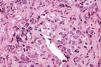

Sr. Director:
El término linfoma de células T/NK extranodal de tipo nasal fue adoptado por la Organización Mundial de la Salud (OMS) sustituyendo al de linfoma angiocéntrico1. Estas neoplasias linfoides pueden presentarse clínicamente en la cabeza y el cuello1, afectando la mucosa de la cavidad nasal; sin embargo, en la región centrofacial son poco frecuentes2. También se han reportado en otras localizaciones tales como la piel, tejidos blandos, testículos, tracto respiratorio superior y tracto gastrointestinal3. La OMS los clasifica en tres categorías principales:
- 1.
Linfoma de células T/NK extranodal de tipo nasal.
- 2.
Enteropático.
- 3.
Similar a la paniculitis subcutánea1.
El linfoma de células T/NK extranodal se encuentra altamente asociado con el virus de Epstein-Barr4.
La piel constituye el segundo sitio más común en donde se desarrollan los linfomas primarios extranodales. Para clasificar un linfoma como primario de piel es requisito no tener evidencia de enfermedad en algún otro sitio, por lo menos en 6 meses previos a la presentación inicial5. Los linfomas NK primarios de piel son raros; se han descrito infiltraciones secundarias de linfomas NK originados en la mucosa nasal, los cuales tienen un comportamiento agresivo, cursando con destrucción rápida de la piel y tejidos adyacentes6.
Presentamos el caso de una mujer de 73 años de edad sin antecedentes de interés que presentó neoformación indolora en vestíbulo nasal, de 6 meses de evolución, la cual fue aumentando de volumen hasta ulcerar la piel, se extendió afectando la totalidad de la nariz y ambas regiones malares. Era de aspecto ulcerado, necrótico y bordes bien delimitados (fig. 1). La tomografía axial computarizada helicoidal, a través del macizo facial, demostró una extensa lesión que involucraba la fosa nasal izquierda, y que incluía los cartílagos laterales de la misma. No hubo evidencia de extensión intraorbitaria ni intracraneal.
La biopsia demostró una epidermis ulcerada, abundante tejido necrótico y un infiltrado de células pleomórficas con núcleos prominentes dentados que se disponían principalmente en las paredes de los vasos sanguíneos de la dermis y tejido celular subcutáneo (fig. 2).
En la inmunohistoquímica las células neoplásicas fueron positivas para CD56, CD45RO y CD43 y negativas para CD20, CD30 y CD57, con lo que se diagnosticó linfoma no Hodking de células T/NK centrofacial. La reacción en cadena de la polimerasa para virus de Epstein-Barr fue negativa.
El resto de la exploración física y la radiografía de tórax fueron normales.
La paciente fue referida al Servicio de Hematología, en donde se le indicó tratamiento con quimioterapia y radioterapia, que no se efectuó por haber sido rechazado por la paciente, que falleció tres meses después.
Los linfomas de células T/NK extranodales son entidades raras que se presentan en alrededor del 12 % de los linfomas no Hodgkin7, principalmente en la edad adulta, con predominio en la quinta década de la vida3. Son más comunes en individuos de origen asiático que en europeos; sin embargo también son relativamente prevalentes en individuos de Latinoamérica y México2, lo cual sugiere que los antecedentes genéticos pueden tener importancia en el desarrollo de estos linfomas3,4.
Dentro de los diagnósticos diferenciales de esta entidad tenemos la granulomatosis de Wegener e infecciones como la mucormicosis en pacientes inmunodeprimidos.
La célula NK deriva de una célula pluripotencial que expresa CD16, CD56 y CD57, en un principio se relaciona con las células T, y sin embargo se diferencia para formar una línea celular diferente. Corresponden a linfocitos que actúan citotóxicamente sin que exista en el individuo sensibilización previa. Son células con un citoplasma claro, abundante, que contienen gránulos azurofílicos y que expresan el antígeno de superficie CD56. Los linfomas NK son neoplasias raras, clínicamente tienen un curso agresivo y se caracterizan por un infiltrado linfoide angiocéntrico y angiodestructivo; por inmunohistoquímica son CD2+, CD3-, CD7+ /- y CD56+.
En general las neoplasias CD56 positivas tienen un pronóstico pobre con una supervivencia media de 13 meses4. Se ha descrito que los linfomas que presentan una sobreexpresión del gen p53 tienen un pronóstico reservado8.
Se debe diferenciar del linfoma blástico de células NK, el cual se consideró originado por linfocitos NK inmaduros; sin embargo hoy se sabe que su precursor son las células dendríticas plasmo celulares9.
Es importante reconocer la existencia de linfomas de alta agresividad y clasificarlos adecuadamente debido a lo poco común de los casos. Tanto el médico patólogo como el clínico deben tenerlos presentes, hacer un diagnóstico adecuado e iniciar un tratamiento específico rápidamente.
La radioterapia es el tratamiento de elección en enfermedad localizada y generalmente se combina con quimioterapia3. Si los pacientes son manejados con quimioterapia inicialmente se recomienda el uso de radioterapia paliativa o coadyuvante, ya que el beneficio de ésta persiste aun después de la quimioterapia10.